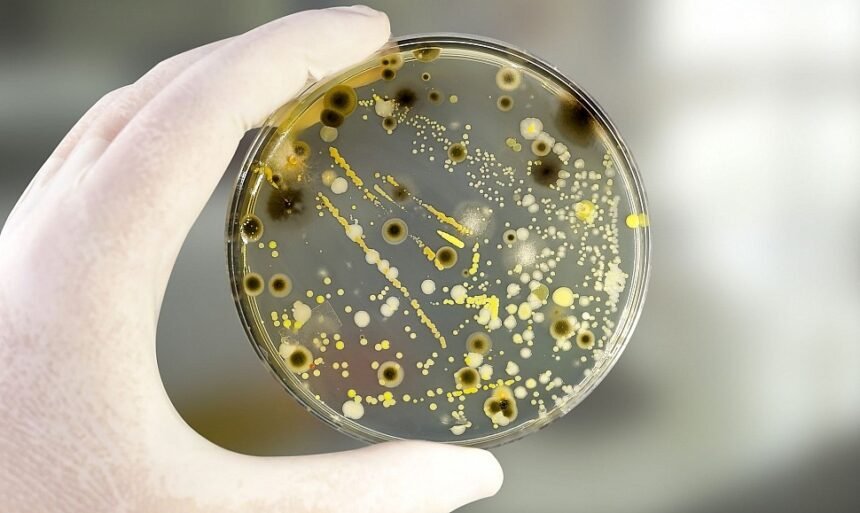

Чашка Петри — це лабораторний посуд, який став символом експериментів у біології, медицині та освіті. Вона використовується для вирощування мікроорганізмів, спостереження за процесами росту клітин та навіть у навчальних експериментах школярів. Сьогодні чашка Петри є одним із найважливіших інструментів, що допомагають вченим робити відкриття.
Що таке чашка Петри
Чашка Петри — це невелика кругла посудина з кришкою, зазвичай виготовлена зі скла або пластику. Її головна перевага полягає в простоті конструкції та зручності у використанні. Саме завдяки своїй формі вона забезпечує оптимальні умови для росту мікроорганізмів і клітин.
Історія винаходу чашки Петри
Винахідником чашки Петри вважається німецький бактеріолог Юліус Ріхард Петри. У 1887 році він працював асистентом Роберта Коха та шукав спосіб створення зручної ємності для вирощування бактерій. З того часу чашка Петри стала незамінною у лабораторній практиці, поширившись по всьому світу.
Матеріали для виготовлення чашки Петри
Сучасні чашки Петри виготовляються з двох основних матеріалів: скла та пластику. Скляні варіанти застосовуються для багаторазового використання, адже їх можна стерилізувати. Пластикові — переважно одноразові, вони широко використовуються у медичних лабораторіях та школах.
Використання чашки Петри у біології

У біології чашка Петрии застосовується для вирощування бактерій, грибів та клітинних культур. Вона дозволяє створити стерильні умови, де можна спостерігати за розвитком живих організмів. Це особливо важливо під час дослідження інфекційних захворювань та розробки нових ліків.
Значення чашки Петри у медицині
У медицині чашка Петрии використовується для діагностики хвороб. Лікарі беруть зразки крові, слини чи інших біологічних матеріалів, поміщають їх у чашку та спостерігають за ростом мікроорганізмів. Це дозволяє визначити інфекції та обрати правильне лікування.
Чашка Петрии в освітньому процесі
У школах та університетах чашка Петрии часто використовується на уроках біології. Учні проводять прості експерименти, наприклад, вирощують цвіль або спостерігають за розвитком бактерій. Це допомагає краще зрозуміти, як працює мікросвіт.
Методи стерилізації чашки Петри
Щоб чашка Петрии була безпечною для досліджень, її потрібно стерилізувати. Найчастіше використовують автоклавування, сухе нагрівання або хімічні розчини. Це забезпечує повну чистоту та виключає сторонні впливи на експеримент.
Чашка Петрии та наукові відкриття

Багато важливих відкриттів у біології та медицині було зроблено завдяки чашці Петри. Наприклад, саме в ній Александер Флемінг відкрив пеніцилін, що врятував мільйони життів. Без цього простого інструмента наука не змогла б досягти таких результатів.
Використання чашки Петри поза наукою
Хоча чашка Петрии здебільшого асоціюється з лабораторіями, вона іноді використовується й у творчості. Деякі художники створюють мікробні картини, вирощуючи кольорові культури у вигляді візерунків. Це поєднання науки та мистецтва викликає захоплення.
Майбутнє чашки Петри
У майбутньому чашка Петрии залишатиметься важливим інструментом. Вчені вже створюють вдосконалені версії, які дозволяють точніше контролювати умови росту клітин. Такі інновації сприятимуть розвитку біотехнологій та медицини.
Чашка Петрии та безпека
Працювати з чашкою Петри потрібно обережно, адже вона може містити небезпечні мікроорганізми. Усі експерименти мають проводитися під наглядом фахівців або в умовах спеціально обладнаних лабораторій.
Висновок
Чашка Петри — це простий, але надзвичайно важливий інструмент у світі науки. Вона стала основою для відкриттів у біології, медицині та освіті. Її значення не зменшується навіть у XXI столітті, адже без неї неможливо уявити сучасні дослідження.
Читати далі: День ангела Наталії – традиції, привітання та історія свята
Часті запитання: Чашка Петри
Чашка Петри — це кругла лабораторна посудина з кришкою, що використовується для вирощування мікроорганізмів і клітин.
Її винайшов німецький бактеріолог Юліус Ріхард Петри у 1887 році.
Чашка Петри застосовується в біології, медицині та навчальному процесі.
Найчастіше використовують автоклав, сухе нагрівання або хімічні дезінфектанти.
Вона дозволяє вченим досліджувати мікроорганізми та створювати нові ліки, що рятують життя.